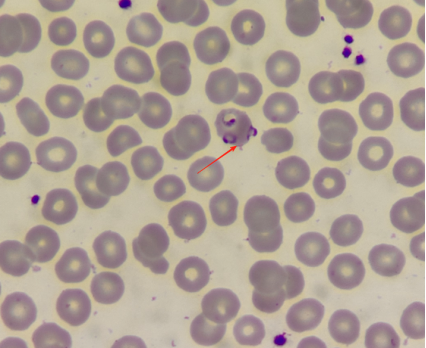
图片

大众卫生报·新湖南客户端7月23日讯(通讯员 沈湘云 小姿)近日,长沙泰和医院检验科通过血涂片检测出一例疟原虫感染的病例,经市疾控确认为恶性疟原虫感染。检验科是怎样通过血涂片发现疟原虫感染的呢?那是因为我们在红细胞中发现了“小戒指”。
 图为疟原虫环状体
图为疟原虫环状体10岁的小马(化名)从非洲旅居回国度假,返回长沙后3天内反复出现发烧,伴有精神萎靡、食欲不振、呕吐等症状,前往长沙泰和医院儿科就诊。接诊医生详细询问得知其有非洲旅居史后,高度怀疑疟疾感染,立即开具血常规及疟原虫快速检测。当血涂片制备完成,检验科的检验人员在显微镜下发现了疟原虫环状体,疑似感染疟原虫,后经疾控确诊为恶性疟。现患者得到了及时的进一步诊疗。

疟原虫是一种单细胞寄生性原生动物,主要通过受感染的雌性按蚊叮咬传播,感染人体后可导致疟疾。疟疾主要流行于热带和亚热带地区,典型临床症状为周期性的寒战、高热、出汗,伴头痛、乏力、呕吐、食欲不振及四肢关节酸痛等,民间俗称“打摆子”。因个人免疫差异和感染疟原虫虫株不同,疟原虫感染后的临床表现也不同,也可能无明显临床症状或出现腹泻等不典型症状。

检验科副主任李晓阳介绍说,恶性疟是疟疾的一种分型,病情进展快,如不及时治疗,很可能引起重症或者死亡。患者有个体差异,有的人发热到死亡可能就2天的时间,耽误不起!在非洲部分地区,感染疟疾和感冒一样容易。需要注意的是:疟疾不是只靠自身免疫力就能康复的疾病,必须尽快治疗!
疟疾主要通过雌按蚊叮咬传播,当雌按蚊叮咬了疟疾病人或带虫者后,再叮咬健康人,就会把疟原虫传给他人。少数可经输血传播,偶有患病孕妇经胎盘感染胎儿。

疟疾不会通过日常接触(如握手、共用餐具)传播,也不会通过空气、食物或水传播。
常用的疟原虫检测方法有病原学检测(瑞氏/吉氏染色镜检)、免疫学检测(酶联免疫吸附试验、间接免疫荧光试验、快速检测实验)、分子生物学检测(聚合酶链式反应)。血常规作为基础筛查项目,有相关研究表明确诊疟疾的患者血常规中WBC、RBC、Hb、Plt的数量均至少有一项明显降低。
尽管疟原虫免疫学检测、疟原虫核酸检测已经被列入确诊疟疾的实验室检查方法,但血涂片(厚、薄血膜)显微镜检查依然是最直接、简单、普及以及时效性强的检查方法。

✅前往疟疾流行国家和地区前,了解当地疟疾流行情况,做好防蚊和药物预防。
✅到达疟疾流行国家和地区时,尽量避免野外活动,个人防护为穿长袖衣裤,使用蚊帐,纱窗、驱虫剂等防蚊措施,避免蚊虫叮咬。
✅离开疟疾流行国家和地区后,出现发热、发冷、出汗等症状及时就医,并告知医生旅居史。
疟疾虽在我国已被消除,但全球疫情仍然存在。如果您或家人近期曾前往疟疾流行病区并出现发热症状,请立即到医院就诊并主动告知医生旅行史。做到“早发现、早治疗”,严防输入再传播,巩固消除疟疾成果。
责编:王璐
一审:王璐
二审:陈艳阳
三审:谢峰

 湖南日报新媒体
湖南日报新媒体




